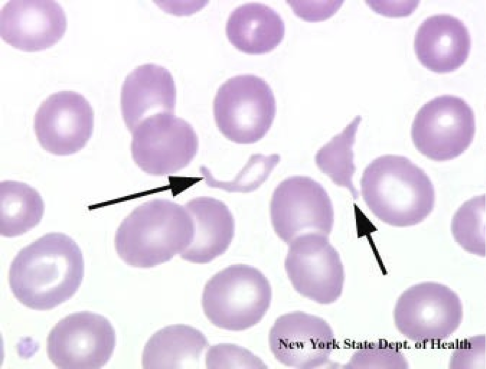

Sign up for FlowVella
Sign up with FacebookAlready have an account? Sign in now
By registering you are agreeing to our
Terms of Service
Loading Flow

Schistocyte
The only description that is most helpful would be that they are fragmented rbc and are usually compared to ketatocytes.
Common diseases/conditions are prosthetic heart valves malignant, severe valvular stenosis, and hypertension microanfiopathic.